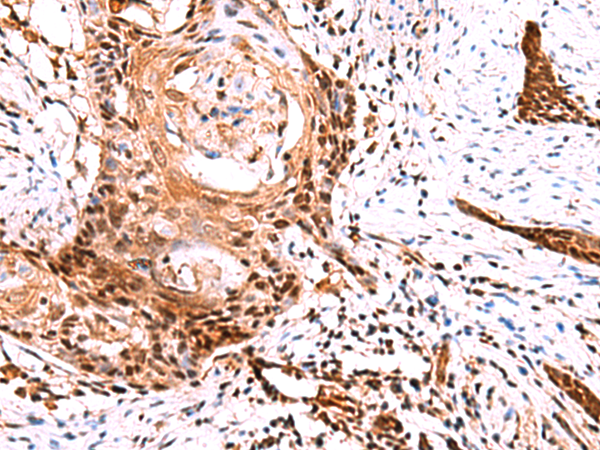

中文名稱: 兔抗TSEN2多克隆抗體
|
Background: |
This gene encodes one of the subunits of the tRNA splicing endonuclease. This endonuclease catalyzes the first step in RNA splicing which is the removal of introns. Mutations in this gene have been associated with pontocerebellar hypoplasia type 2. A pseudogene has been identified on chromosome 4. Multiple transcript variants encoding different isoforms have been found for this gene. |
|
Applications: |
ELISA, IHC |
|
Name of antibody: |
TSEN2 |
|
Immunogen: |
Fusion protein of human TSEN2 |
|
Full name: |
tRNA splicing endonuclease subunit 2 |
|
Synonyms: |
SEN2; PCH2B; SEN2L |
|
SwissProt: |
Q8NCE0 |
|
ELISA Recommended dilution: |
5000-10000 |
|
IHC positive control: |
Human esophagus cancer |
|
IHC Recommend dilution: |
50-300 |
購(gòu)物車
幫助
021-54845833/15800441009
